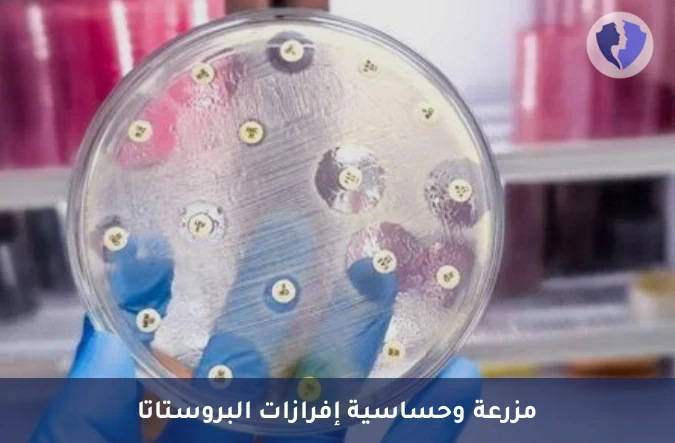
مزرعة إفرازات البروستاتا - مزرعة وحساسية إفرازات البروستاتا

تفاصيل الخدمة
مزرعة إفرازات البروستاتا - مزرعة وحساسية إفرازات البروستاتا
باقة تشخيصية متخصصة لعدوى البروستاتا (التهاب البروستاتا الجرثومي). تشمل الزراعة الكمية لعينة البول بعد تدليك البروستاتا (مقارنة بعينات البول الأخرى)، أو لعينة إفراز البروستاتا نفسها، على أوساط مغذية. كما تشمل اختبار الحساسية للمضادات الحيوية للبكتيريا المعزولة لتحديد أنسب مضاد حيوي للعلاج، والذي يجب أن يتمتع بقدرة جيدة على اختراق أنسجة البروستاتا.